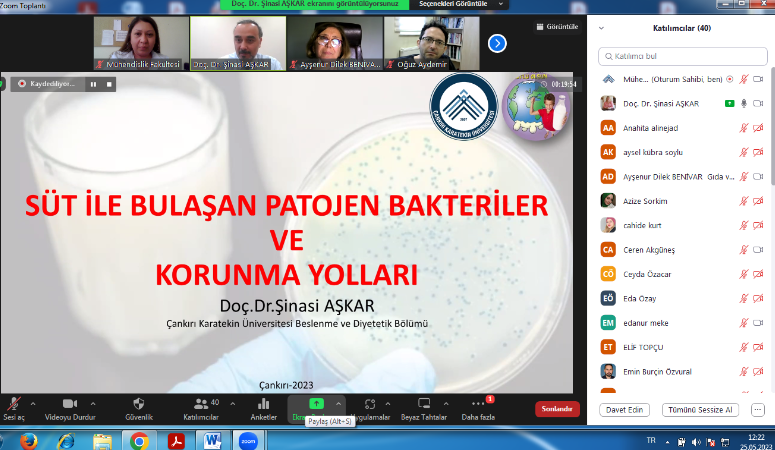
Çankırı Karatekin Üniversitesi (ÇAKÜ) ile Çankırı Tarım Orman İl Müdürlüğü

Çankırı Karatekin Üniversitesi (ÇAKÜ) ile Çankırı Tarım Orman İl Müdürlüğü tarafından “Dünya Süt Günü Paneli” gerçekleştirildi.
“Süt ve Sağlık” başlığıyla gerçekleştirilen panele, konuşmacı olarak ÇAKÜ Gıda Mühendisliği Bölümünden Doç. Dr. Oğuz Aydemir ile Dr. Öğr. Üyesi Seda Özgen ve Beslenme ve Diyetetik Bölümünden Doç. Dr. Şinasi Aşkar katılırken Çankırı Tarım ve Orman İl Müdürlüğünden ise Gıda ve Yem Şube Müdürü Mühendis Ayşenur Dilek Benivar katıldı.
Sütün sağlık açısından faydaları, sağlıklı süt tüketimi; sütte oluşabilecek fiziksel, kimyasal ve mikrobiyolojik bozulmalar ve bunlardan kaynaklanan sorunların ele alındığı panelde, Çankırı’nın süt üretimiyle süt işletmeleri açısından mevcut durumu, yaşanan problemler ve süt ürünleri mevzuatı hakkında da bilgilendirmelerde bulunuldu.